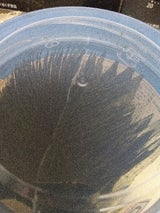
商品画像

袋のゴミも出ないし空容器も活用したいと思っています
白子 白子 卓上味おかず香 10切 80枚 の口コミ・評判
総合評価 4.07
- 評価件数:
- 153件
- 口コミ件数:
- 47件
- 評価ランキング:
- 1,577位
- 売れ筋ランキング:
- 254位
- 【のり】カテゴリ内 3,194商品中
商品情報
| カテゴリ | のり |
|---|---|
| メーカー | 白子 |
| JANコード | 4901673262664 |
購入者の口コミ(47件)
ものログは、レシート等で購入証明された「実際に買った人」からの口コミ・評価・購買情報だけを掲載しています。
口コミについて
口コミの集計データ日時
2014年6月~読み込み中...
※参照データ:CODEアプリのユーザーが登録した購買データ(レシートと商品バーコードをスキャン)
口コミの留意点
- 口コミ・★評価はあくまで投稿者個人の感想です。また、個人差等があります。
- 当社は口コミ・評価の正確性・有用性・当否などについて何らかの保証をすることはできません。ご自身の判断でお読みください。
- 本サービスは情報の集約をしていますが、口コミ・評価に係る特定の商品を推せんしたり、特定の商品への誘引を意図したりするものではありません。
高評価と低評価について
- 高/低評価の判断基準は口コミの★評価(★0.5~5)によって決まります。
- 高評価:★4~5がついた口コミ
- 低評価:★0.5~2がついた口コミ
※ 口コミが一定数に達していないページに関しては、高評価・低評価の口コミ分類をおこなっておりません。
※ 評価点数の基準はこちらをご参照ください。
梱包されていないおかずのりなので ついつい食べすぎてしまうので注意という広告がとてもすごい、それだけ自信を持っているということだろうか のりば塩辛すぎないところがとてもよく丁度いい塩気があるのがいい パリッともあるしまろやかさももっている
初めて購入して味わってみました⤴︎ご飯🍚によく合います👍 娘はそのままパリパリおやつ感覚で食べていました〜 凄く美味しかったようです😋 一度にバリバリ食べて半分以上減ってしまったので、早すぎ‼︎ また購入しなくては… (*^ω^*)
今まで食べていた海苔がもっと甘めだったので、それよりしょっぱく感じて残念でした。 慣れるとおいしいです。
ご飯に巻いて食べるのはもちろん、そのまま子供のおやっ代わりになっています。 甘じょっぱくて止まらない!
個包装の入数がどんどん減っているので、卓上にしました。新米の美味しい季節に沢山食べたいと思います。
白子のりなので安心して購入しましたが 正直残念です 味が薄味で旨みも少なく本当にガッカリです
半額だったので購入。一度に使い切らなければならないわけじゃないので、気を使う必要なし。
お得なので買ってみました!まだ食べてませんが明日の朝ごはん楽しみです!
安売りだったので買いました。卓上だと好きなだけ食べられるので有難い。
美味しかったですが、もう少し甘めが好みなので、リピはしませんね、、
ふたのテープを剥がすのに苦戦しました。 剥がしにくいです。。
ご飯にも合うし、そのまま食べても美味しいです。
お弁当、食卓兼用で使ってます。美味しいです。
個包装でないのでしけるのが早いが、味は良い。
のりご飯でとても美味しくいただきました。
まだ食べてないけど安かったので買った!
海苔の風味もまあまああり、美味しい。
海苔が大好きなのでよく買います
天の方が上だが、 これもあり。
朝御飯にいつも食べてます。
白いご飯に海苔が美味しい
ちょっとごわごわしてる。
好みの味ではなかった
コスパ良くて美味しい
美味しくてたっぷり
パリパリ、おいしい
夫が買って来ました
初めて買ってみた
食べやすいです!
子どもが大好き。
美味しかったです
なくなったので
ライフは高い…
安い、美味い!
あると安心です
ご飯が進みます
朝食のお供に
美味しいかな
おかずのり
美味かった
使いやすい
普通です。
朝ごはんに
味が薄い
美味
👍
購入店舗と価格
- アピレ赤羽¥438
- ディスカウントドラッグコスモス西大宮店¥412
- ドンキホーテ¥199
- ウエルシア佐倉小竹店¥518
- ウエルシア高松朝日町店¥518
- まるごう米子南店¥528
- ウエルシア市原能満店¥518
- ウエルシア所沢上新井店¥518
- ハックドラッグ戸塚汲沢店¥518
- ディスカウントドラッグコスモス六高台店¥458